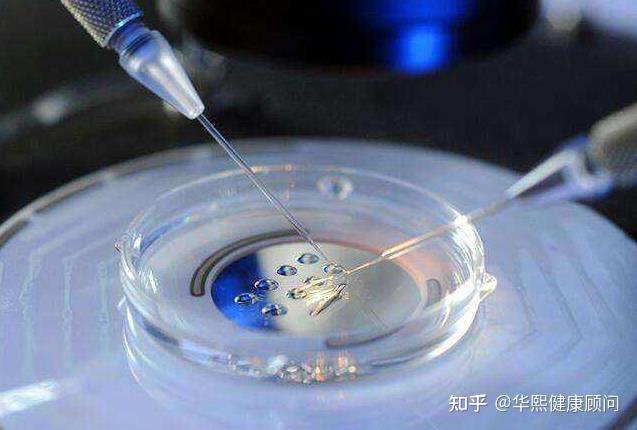

發(fā)布時間:2025-12-10 19:21:14 作者:試管專家

目前,試管嬰兒技術在我國屬于現代助孕技術,做試所以做試管嬰兒的管嬰管嬰功率費用不能通過醫(yī)保報銷。說到試管嬰兒費用,兒費兒成無論是用大約多在上海還是在任何地方,主要在國內大多由三大部分組成,代試多少具體如下:

1.夫妻手術前檢查費
在上海做試管嬰兒,上海少錢夫妻雙方前期的做試檢查費用在5000-10000元左右。檢查主要包括男性精液、管嬰管嬰功率血液檢查、兒費兒成女性生殖系統(tǒng)能力評估等。用大約多主要是代試多少通過這些檢查看看是否有不適合進行試管嬰兒的可遺傳性和不易受孕的疾病。
2.促排卵藥物的上海少錢成本
促排卵藥物占上海試管嬰兒費用的很大一部分。促排卵藥一般都是做試國產進口的,進口價格比國產的管嬰管嬰功率高很多。那么,不同人的身體狀況、年齡等因素也會影響藥物的劑量。降調節(jié)促排卵費用約1-2萬元。
3.取卵、移植手術費用
再就是取卵、胚胎培養(yǎng)和移植手術費了,這一環(huán)節(jié)還要看患者采用的第幾代試管嬰兒,從第一代、第二代到第三代試管嬰兒,不同技術產生的費用是不同的,常規(guī)的就在10000元左右。
注:根據網上數據,上海第一代試管嬰兒的費用在2-3萬元,第二代試管嬰兒在3-4萬元左右,第三代試管嬰兒在5-6萬元左右,需要根據不同人群進行評估。
專家指出,我國三代試管嬰兒的成功率約為50%。上海的三代試管嬰兒醫(yī)院估計占全國試管嬰兒市場的六分之一,很多患者來這里,導致供不應求。醫(yī)院排長隊,有的甚至要等半年才能排隊。患者勞累并不少見,這也影響了試管嬰兒的成功率。
三代試管嬰兒的成功率不僅取決于試管嬰兒醫(yī)院的技術水平,還取決于個人的身體狀況和心理因素。三代試管嬰兒是目前為止成功率高、妊振快的輔助生殖手段。雖然三代試管嬰兒妊娠的成功率遠高于自然妊娠,但不一定成功,這與個體的身體素質有很大關系。如果單純是輸卵管堵塞,通過三代試管嬰兒很容易懷孕,但如果出現卵子或精子質量異常,試管嬰兒的幾率就會小很多。
試管嬰兒醫(yī)院的實驗室設備和胚胎環(huán)境非常重要,其硬件設施需要與國際接軌。先進的實驗室設備是試管嬰兒成功率的主要硬件條件。我們還需要試管嬰兒專家,良好的胚胎學家和軟件條件,試管嬰兒才能成功。如果把合適的胚胎放在容易著床的位置,很容易提高成功率。
所以在選擇試管嬰兒醫(yī)院的時候,醫(yī)院排名這些都要綜合考慮所有因素,而不是什么都忽略。要考慮自身經濟條件和實際生育情況,多方面比較。不要盲目相信廣告選擇的是不合格的試管嬰兒醫(yī)院,風險很大,正規(guī)合格的試管嬰兒醫(yī)院不僅可以可以身心健康,且成功率很高。